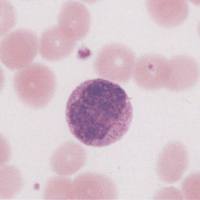
囊胚注射

- 详细信息
- 技术资料
贴壁细胞的传代
1 入无菌室之前首先要用肥皂或洗手液洗手,用灭溶液擦拭双手消毒。
2 打开超净工作台的紫外消毒灯(紫外消毒20-30min)。从CO2培养箱取出培养细胞,倒置显微镜下观察细胞形态和生长密度,确定细胞是否需要传代及细胞需要稀释的倍数。将培养用液置于37℃下预热。
3 关闭已照射超净工作台20min左右的紫外灯,打开抽风机清洁空气,除去臭氧。
4 点燃酒精灯,用75%乙醇擦拭双手消毒,并擦净台面。
5 将培养用液瓶身用75%酒精檫拭消毒后放入操作台内。
6 从培养箱中取出细胞培养瓶,经75%酒精喷洒消毒后立放于操作台内。
7 倒掉细胞旧培养液,4ml PBS洗涤两遍,解除残留血清对胰蛋白酶的抑制作用。
8 向培养瓶(25cm2)加入1ml的胰酶消化液,小瓶用量酬减。
9 盖好瓶盖后在倒置显微镜下观察,立刻放入培养箱中消化,一般1-2min。
10 当细胞突起收回即将变圆时立即取出。
11 加入5ml含血清的新鲜培养基,反复吹打贴壁细胞的培养瓶底部使消化好的细胞脱壁并分散,移入10ml离心管中,800 r/min,2min。
12 加入1-2ml培养基制成细胞悬液并计数。根据计数结果,按每个小方瓶2×105接种细胞传代培养。
13 盖上瓶盖,适度柠紧后再稍旋回,给出空气通道,以利于CO2气体的进出,将培养瓶放回培养箱。
1 入无菌室之前首先要用肥皂或洗手液洗手,用灭溶液擦拭双手消毒。
2 打开超净工作台的紫外消毒灯(紫外消毒20-30min)。从CO2培养箱取出培养细胞,倒置显微镜下观察细胞形态和生长密度,确定细胞是否需要传代及细胞需要稀释的倍数。将培养用液置于37℃下预热。
3 关闭已照射超净工作台20min左右的紫外灯,打开抽风机清洁空气,除去臭氧。
4 点燃酒精灯,用75%乙醇擦拭双手消毒,并擦净台面。
5 将培养用液瓶身用75%酒精檫拭消毒后放入操作台内。
6 从培养箱中取出细胞培养瓶,经75%酒精喷洒消毒后立放于操作台内。
7 倒掉细胞旧培养液,4ml PBS洗涤两遍,解除残留血清对胰蛋白酶的抑制作用。
8 向培养瓶(25cm2)加入1ml的胰酶消化液,小瓶用量酬减。
9 盖好瓶盖后在倒置显微镜下观察,立刻放入培养箱中消化,一般1-2min。
10 当细胞突起收回即将变圆时立即取出。
11 加入5ml含血清的新鲜培养基,反复吹打贴壁细胞的培养瓶底部使消化好的细胞脱壁并分散,移入10ml离心管中,800 r/min,2min。
12 加入1-2ml培养基制成细胞悬液并计数。根据计数结果,按每个小方瓶2×105接种细胞传代培养。
13 盖上瓶盖,适度柠紧后再稍旋回,给出空气通道,以利于CO2气体的进出,将培养瓶放回培养箱。
风险提示:丁香通仅作为第三方平台,为商家信息发布提供平台空间。用户咨询产品时请注意保护个人信息及财产安全,合理判断,谨慎选购商品,商家和用户对交易行为负责。对于医疗器械类产品,请先查证核实企业经营资质和医疗器械产品注册证情况。
技术资料暂无技术资料 索取技术资料
动物细胞传代培养
询价